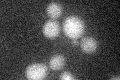
YNL128W
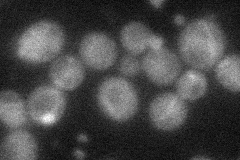
YNL128W
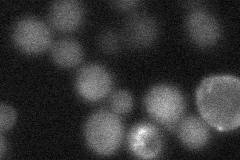
YNL128W

View description
Homolog of human tumor suppressor gene PTEN/MMAC1/TEP1 that has lipid phosphatase activity and is linked to the phosphatidylinositol signaling pathway; plays a role in normal sporulation
Localization:
Intensity:
Fold change:
Significance:
-
C’ GFP library in SD
below threshold15.25 -
N' NOP1pr-GFP in SD
cytosol34.6974 -
N' TEF2pr-mCherry in SD
cytosol16.9507 -
N' NATIVEpr-GFP in SD

below threshold15.3719 -
N' TEF2pr-VC and Cyto-VN in SD

below threshold27.1884 -
C’ GFP library in SD+DTT

cytosol16.51.08No -
C’ GFP library in SD+H2O2

cytosol17.231.12No -
C’ GFP library in Starvation Media

cytosol16.871.1No -
C’ GFP library on the background of Pup2-DaMP

below threshold -
C’ GFP library on the background of CCT mutant

below threshold17.15081.12437No
